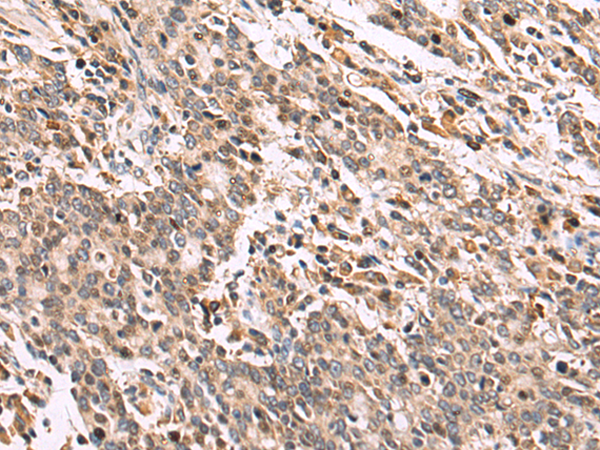

|
Background: |
Troponin proteins associate with tropomyosin and regulate the calcium sensitivity of the myofibril contractile apparatus of striated muscles. Troponin I (TnI), along with troponin T (TnT) and troponin C (TnC), is one of 3 subunits that form the troponin complex of the thin filaments of striated muscle. TnI is the inhibitory subunit; blocking actin-myosin interactions and thereby mediating striated muscle relaxation. The TnI subfamily contains three genes: TnI-skeletal-fast-twitch, TnI-skeletal-slow-twitch, and TnI-cardiac. The TnI-fast and TnI-slow genes are expressed in fast-twitch and slow-twitch skeletal muscle fibers, respectively, while the TnI-cardiac gene is expressed exclusively in cardiac muscle tissue. This gene encodes the Troponin-I-skeletal-slow-twitch protein. This gene is expressed in cardiac and skeletal muscle during early development but is restricted to slow-twitch skeletal muscle fibers in adults. The encoded protein prevents muscle contraction by inhibiting calcium-mediated conformational changes in actin-myosin complexes. |
|
Applications: |
ELISA, IHC |
|
Name of antibody: |
TNNI1 |
|
Immunogen: |
Fusion protein of human TNNI1 |
|
Full name: |
troponin I1, slow skeletal type |
|
Synonyms: |
TNN1; SSTNI |
|
SwissProt: |
P19237 |
|
ELISA Recommended dilution: |
5000-10000 |
|
IHC positive control: |
Human liver cancer |
|
IHC Recommend dilution: |
50-100 |
購物車
幫助
021-54845833/15800441009
